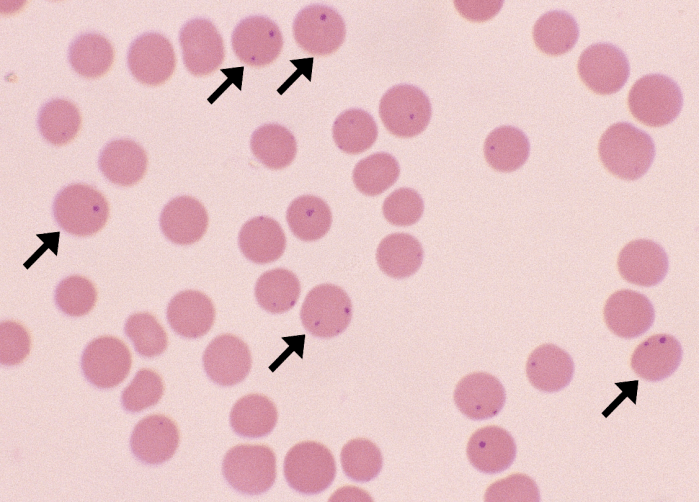
Anaplasma marginale 1 ARROWS

Anaplasma marginale
Morphology: small, round, dark purple inclusions located at the periphery of red cells. Usually 1 – 2 bacteria per red cell. Present in up to 90% of red cells.
Look alike: Howell-Jolly bodies
Clinical relevance: Anaplasma marginale is an intracellular bacteria that infects erythrocytes of cattle. Causes severe acute hemolytic anemia.


